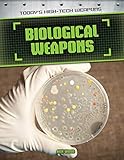
Amazon cover image

Results
|
|
1.
|

Image from Amazon.com
|
|
|
|
2.
|
Image from Amazon.com
|
Biological weapons/ Alix Wood. by Series: Wood, Alix. Today's high-tech weapons ;
Material type:  Text; Format:
print
; Literary form:
Not fiction
; Audience:
Juvenile; Text; Format:
print
; Literary form:
Not fiction
; Audience:
Juvenile;
Publisher: New York : PowerKids Press, 2016Publisher: [Place of publication not identified] : [Publisher not identified], 2016
Availability: Items available for loan: John Tomay Memorial Library (1)Call number: J 358 WOO.
|
|
|
3.
|
|
Inferno / Columbia Pictures and Imagine Entertainment present ; in association with LStar Capital ; a Brian Grazer production ; a Ron Howard film ; produced by Brian Grazer, Ron Howard ; screenplay by David Koepp ; directed by Ron Howard. by
- Grazer, Brian, 1953- [Film producer, Producer]
- Koepp, David [Screenwriter]
- Howard, Ron, 1954- [Film producer, Film director, Director, Producer]
- Hanks, Tom [Actor]
- Jones, Felicity [Actor]
- Khan, Irrfan, 1962- [Actor]
- Sy, Omar, 1978- [Actor]
- Foster, Ben, 1980- [Actor]
- Knudsen, Sidse Babett [Actor]
- Ularu, Ana, 1985- [Actor]
- Zimmer, Hans [Musical director]
- Brown, Dan, 1964-. Inferno
- Sony Pictures Home Entertainment (Firm) [Publisher]
- Columbia Pictures [Presenter]
- Imagine Entertainment (Firm) [Presenter]
- LStar Capital (Firm) [Presenter]
Edition: Widescreen (1.85:1)
Material type:  Film; Type of visual material:
videorecording
; Audience:
General; Film; Type of visual material:
videorecording
; Audience:
General;
Language: English Summary language: English, Spanish Original language: English Publisher: Culver City, CA : Sony Pictures Home Entertainment, [2017]Copyright date: ©2017
Availability: Items available for loan: Idaho Springs Public Library (1)Call number: DVD FIC DAV.
|
|
|
4.
|

Image from Amazon.com
|
The coldest warrior / Paul Vidich. by
Edition: First Pegasus books hardcover edition.
Material type:  Text; Format:
print
; Literary form:
Fiction Text; Format:
print
; Literary form:
Fiction
Publisher: New York, : Pegasus Crime is an imprint of Pegasus Books, Ltd., 2020Copyright date: ©2020
Availability: Items available for loan: Idaho Springs Public Library (1)Call number: FIC VID.
|